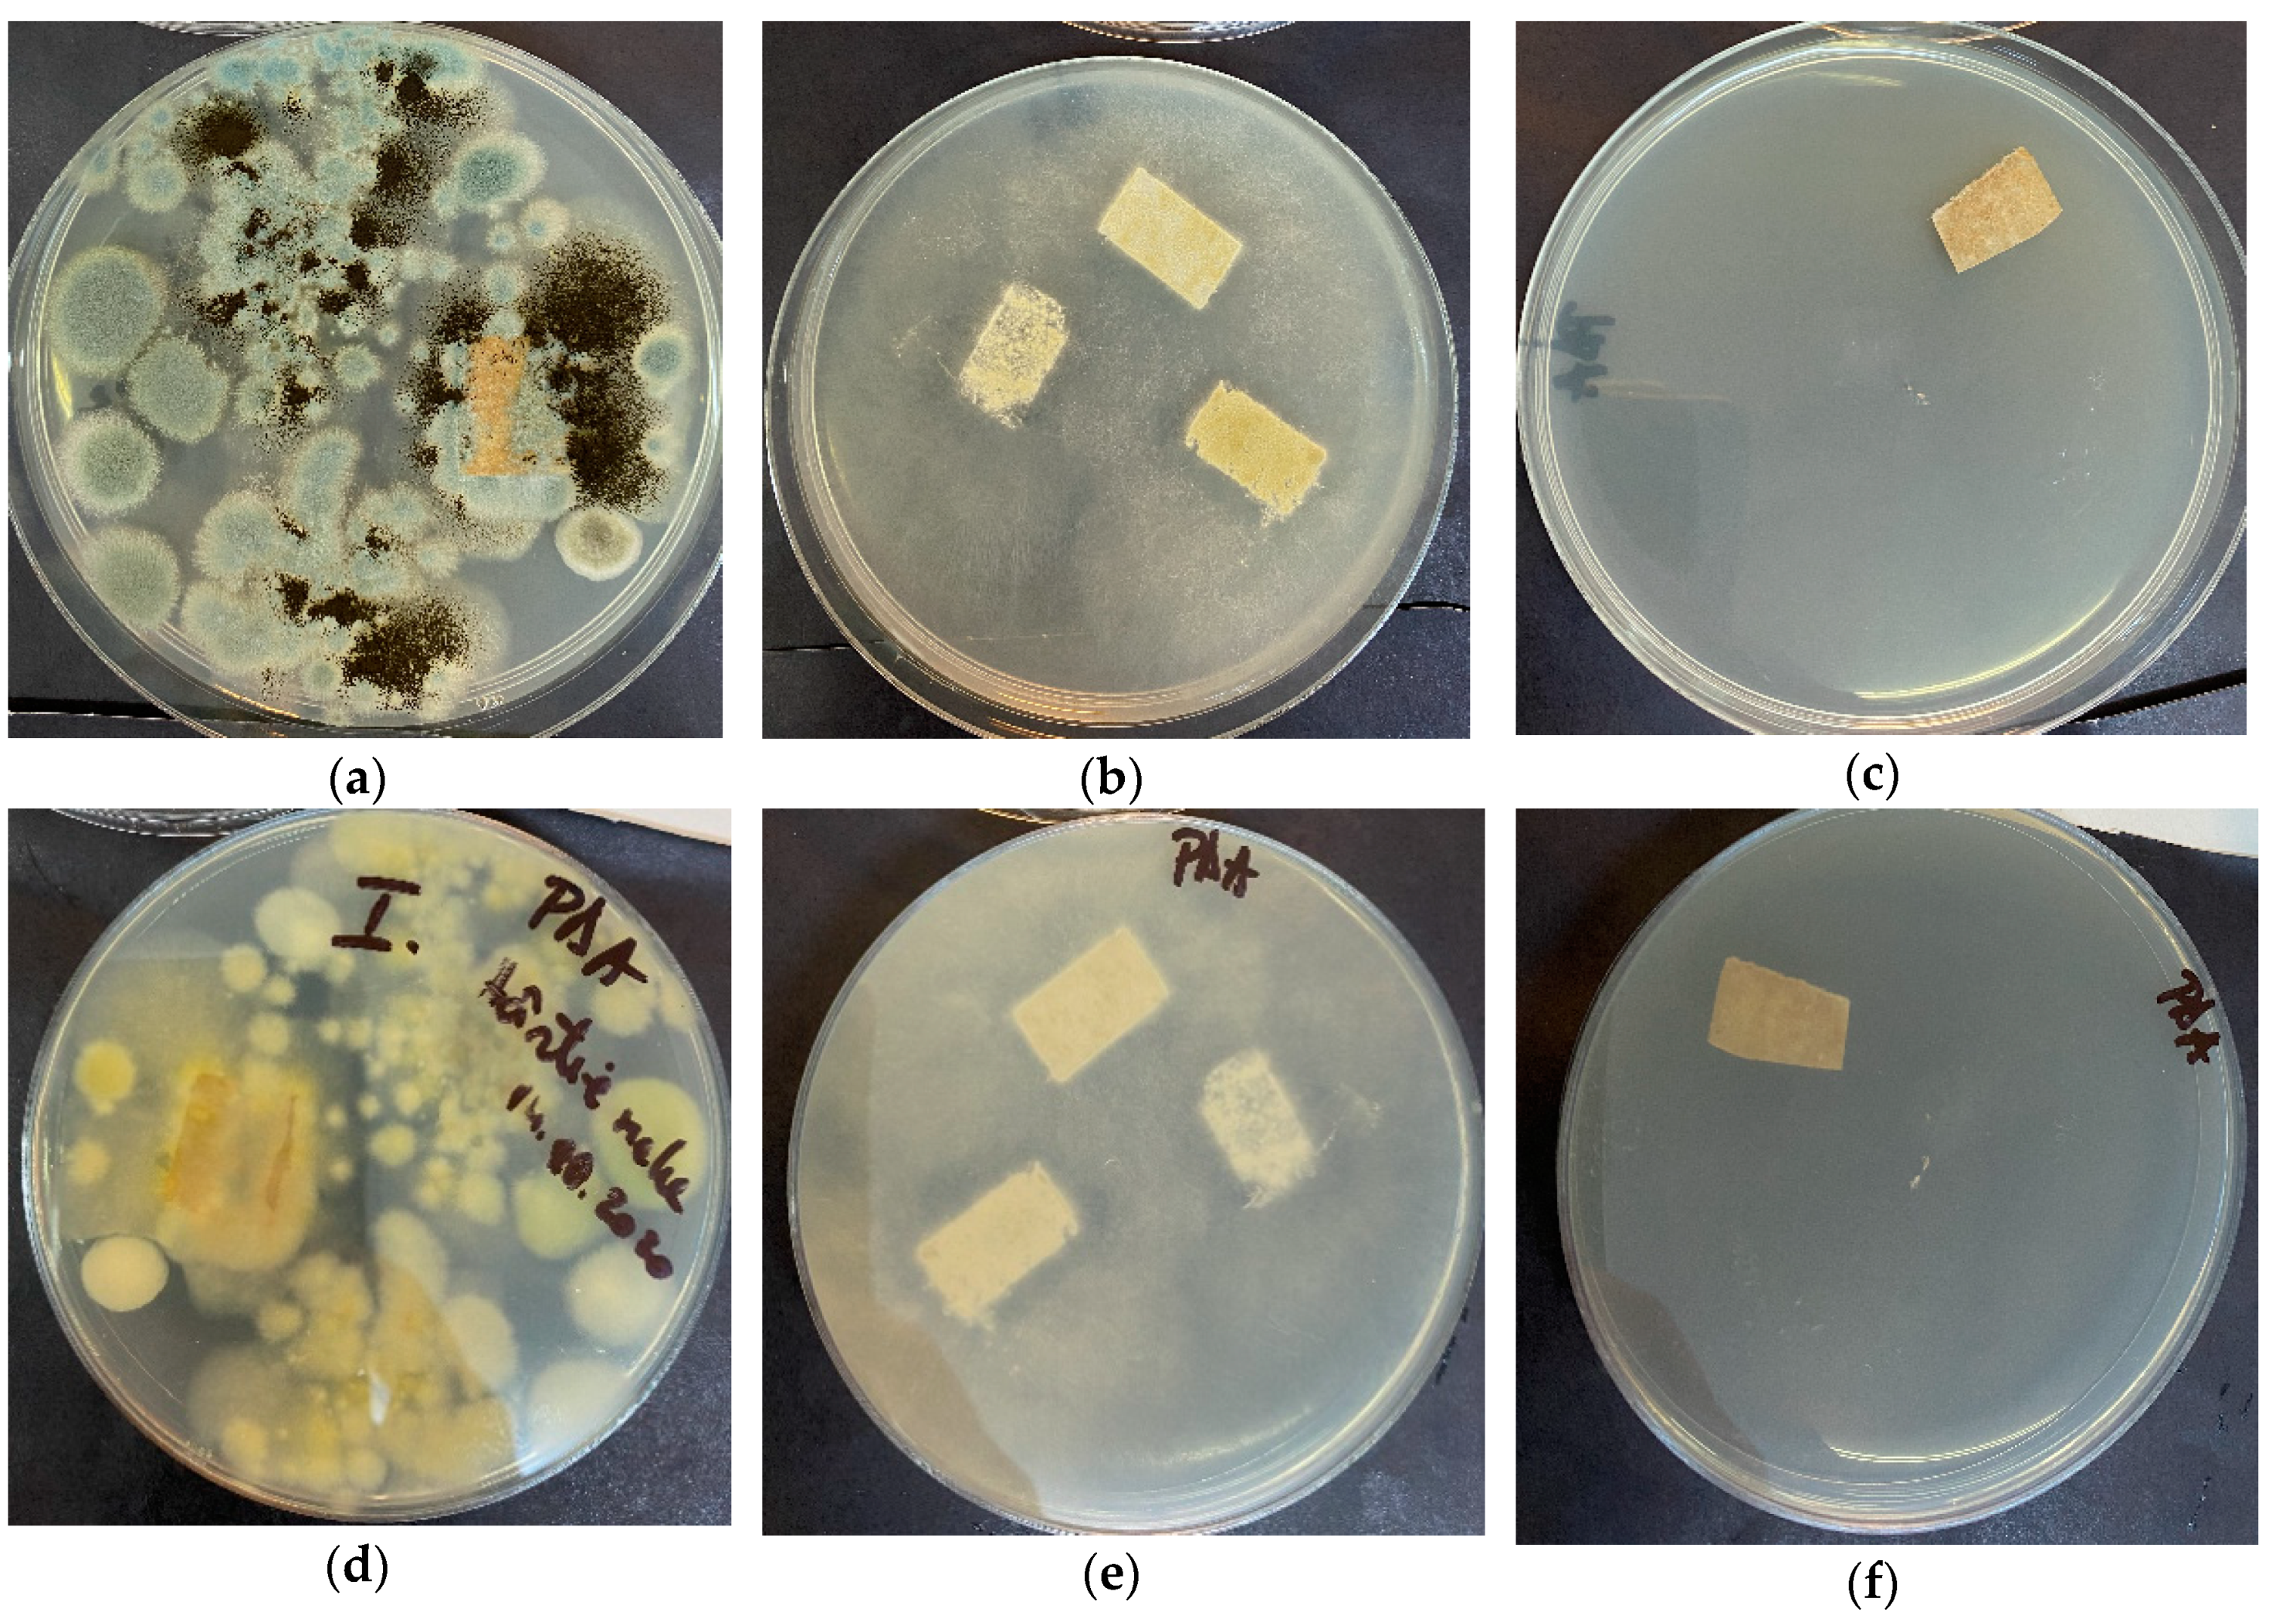

Facile Use of ZnO Nanopowders to Protect Old Manual Paper Documents
Abstract
1. Introduction
2. Materials and Methods
2.1. Materials
2.2. Characterization of ZnO Nanoparticles and Paper Samples
2.3. Antimicrobial Evaluation
2.3.1. Antibacterial Activity
2.3.2. Microfungal (Mold) Removal
3. Results and Discussion
3.1. Transmission Electron Microscopy (TEM)
3.2. X-ray Powder Diffraction (XRD)
3.3. UV-Vis and PL Spectrometry
3.4. Photocatalytic Activity
3.5. Antimicrobial Activity
3.6. Scanning Electron Microscopy (SEM) of Old Documents Paper
3.7. FTIR Microscopy of Old Documents Paper
3.8. UV-Vis and PL Ppectrometry on Old Documents Paper
3.9. Antimicrobial Assay for Paper Samples before and after Treatment with ZnO
4. Conclusions
Author Contributions
Funding
Conflicts of Interest
References
- Amini, E.; Azadfallah, M. In situ synthesis of silver nanoparticles on fiber matrix for preparing antibacterial paper. Biointerface Res. Appl. Chem. 2018, 8, 3449–3456. [Google Scholar]
- Brown, N.; Lichtblau, D.; Fearn, T.; Strlic, M. Characterisation of 19th and 20th century Chinese paper. Herit. Sci. 2017, 5. [Google Scholar] [CrossRef]
- Barrett, T.; Ormsby, M.; Lang, J. Non-Destructive Analysis of 14th–19th Century European Handmade Papers. Restaur. Int. J. Preserv. Libr. Arch. Mater. 2016, 37, 93–135. [Google Scholar] [CrossRef]
- Area, M.C.; Cheradame, H. Paper Aging and Degradation: Recent Findings and Research Methods. Bioresources 2011, 6, 5307–5337. [Google Scholar]
- Flint, H.J.; Scott, K.P.; Duncan, S.H.; Louis, P.; Forano, E. Microbial degradation of complex carbohydrates in the gut. Gut Microbes 2012, 3, 289–306. [Google Scholar] [CrossRef]
- Jo, H.J.; Joo, S.M.; Kim, J.Y.; Yu, K.H.; Kim, S.W. Development of a Hybrid Chitosan- and Niacinamide-Coupled ZnO Nanoparticle Composite for Sun Protection Application. J. Nanomater. 2019, 2019. [Google Scholar] [CrossRef]
- Nazir, S.; Rabbani, A.; Mehmood, K.; Maqbool, F.; Shah, G.M.; Khan, M.F.; Sajid, M. Antileishmanial activity and cytotoxicity of ZnO-based nano-formulations. Int. J. Nanomed. 2019, 14, 7809–7822. [Google Scholar] [CrossRef]
- Nada, A.A.; Selim, H.; Bechelany, M.; El-Sayed, M.; Hegazey, R.M.; Souaya, E.R.; Kotkata, M.F. A novel photoelectrode of NiO@ZnO nanocomposite prepared by Pechini method coupled with PLD for efficiency enhancement in DSSCs. Mater. Sci. 2018, 36, 327–336. [Google Scholar] [CrossRef]
- Deyab, M.A.; Nada, A.A.; Hamdy, A. Comparative study on the corrosion and mechanical properties of nano-composite coatings incorporated with TiO2 nano-particles, TiO2 nano-tubes, and ZnO nano-flowers. Prog. Org. Coat. 2017, 105, 245–251. [Google Scholar] [CrossRef]
- Oprea, O.; Andronescu, E.; Ficai, D.; Ficai, A.; Oktar, F.N.; Yetmez, M. ZnO Applications and Challenges. Curr. Org. Chem. 2014, 18, 192–203. [Google Scholar] [CrossRef]
- Patino-Herrera, R.; Catarino-Centeno, R.; Robles-Martinez, M.; Zarate, M.G.M.; Flores-Arriaga, J.C.; Perez, E. Antimycotic activity of zinc oxide decorated with silver nanoparticles against Trichophyton mentagrophytes. Powder Technol. 2018, 327, 381–391. [Google Scholar] [CrossRef]
- Wasim, M.; Khan, M.R.; Mushtaq, M.; Naeem, A.; Han, M.C.; Wei, Q.F. Surface Modification of Bacterial Cellulose by Copper and Zinc Oxide Sputter Coating for UV-Resistance/Antistatic/Antibacterial Characteristics. Coatings 2020, 10, 364. [Google Scholar] [CrossRef]
- Sabry, N.M.; Tolba, S.T.M.; Abdel-Gawad, F.K.; Bassem, S.M.; Nassar, H.; El-Taweel, G.E.; Ibrahim, M.A. On the molecular modeling analyses of the interaction between nano zinc oxide and bacteria. Biointerface Res. Appl. Chem. 2018, 8, 3294–3297. [Google Scholar]
- Husain, Q. An overview on the green synthesis of nanoparticles and other nano-materials using enzymes and their potential applications. Biointerface Res. Appl. Chem. 2019, 9, 4255–4271. [Google Scholar]
- Vasile, O.R.; Serdaru, I.; Andronescu, E.; Trusca, R.; Surdu, V.A.; Oprea, O.; Ilie, A.; Vasile, B.S. Influence of the size and the morphology of ZnO nanoparticles on cell viability. Comptes Rendus Chim. 2015, 18, 1335–1343. [Google Scholar] [CrossRef]
- Tymoszuk, A.; Wojnarowicz, J. Zinc Oxide and Zinc Oxide Nanoparticles Impact on In Vitro Germination and Seedling Growth in Allium cepaL. Materials 2020, 13, 2784. [Google Scholar] [CrossRef]
- Taha, A.; Ben Aissa, M.; Da’na, E. Green Synthesis of an Activated Carbon-Supported Ag and ZnO Nanocomposite for Photocatalytic Degradation and Its Antibacterial Activities. Molecules 2020, 25, 1586. [Google Scholar] [CrossRef]
- Shi, L.E.; Li, Z.H.; Zheng, W.; Zhao, Y.F.; Jin, Y.F.; Tang, Z.X. Synthesis, antibacterial activity, antibacterial mechanism and food applications of ZnO nanoparticles: A review. Food Addit. Contam. Part A Chem. Anal. Control Expo. Risk Assess. 2014, 31, 173–186. [Google Scholar] [CrossRef]
- McClements, D.J.; Xiao, H. Is nano safe in foods? Establishing the factors impacting the gastrointestinal fate and toxicity of organic and inorganic food-grade nanoparticles. Sci. Food 2017, 1, 6. [Google Scholar]
- Lee, C.C.; Lin, Y.H.; Hou, W.C.; Li, M.H.; Chang, J.W. Exposure to ZnO/TiO2 Nanoparticles Affects Health Outcomes in Cosmetics Salesclerks. Int. J. Environ. Res. Public Health 2020, 17, 6088. [Google Scholar] [CrossRef]
- Motelica, L.; Ficai, D.; Ficai, A.; Oprea, O.C.; Kaya, D.A.; Andronescu, E. Biodegradable Antimicrobial Food Packaging: Trends and Perspectives. Foods 2020, 9, 1438. [Google Scholar] [CrossRef] [PubMed]
- Vasile, B.S.; Oprea, O.; Voicu, G.; Ficai, A.; Andronescu, E.; Teodorescu, A.; Holban, A. Synthesis and characterization of a novel controlled release zinc oxide/gentamicin-chitosan composite with potential applications in wounds care. Int. J. Pharm. 2014, 463, 161–169. [Google Scholar] [CrossRef] [PubMed]
- Sahu, D.; Kannan, G.M.; Vijayaraghavan, R.; Anand, T.; Khanum, F. Nanosized zinc oxide induces toxicity in human lung cells. ISRN Toxicol. 2013, 2013, 316075. [Google Scholar] [CrossRef] [PubMed]
- Sruthi, S.; Ashtami, J.; Mohanan, P.V. Biomedical application and hidden toxicity of Zinc oxide nanoparticles. Mater. Today Chem. 2018, 10, 175–186. [Google Scholar] [CrossRef]
- Vandebriel, R.J.; De Jong, W.H. A review of mammalian toxicity of ZnO nanoparticles. Nanotechnol. Sci. Appl. 2012, 5, 61–71. [Google Scholar] [CrossRef]
- El Shemy, M.A.; Azab, N.I.; Salim, R.F. Zinc Oxide Nanoparticles: The Hidden Danger. Int. J. Biochem. Biophys. Mol. Biol. 2017, 2, 1–9. [Google Scholar] [CrossRef][Green Version]
- Mohammed, Y.H.; Holmes, A.; Haridass, I.N.; Sanchez, W.Y.; Studier, H.; Grice, J.E.; Benson, H.A.E.; Roberts, M.S. Support for the Safe Use of Zinc Oxide Nanoparticle Sunscreens: Lack of Skin Penetration or Cellular Toxicity after Repeated Application in Volunteers. J. Investig. Dermatol. 2019, 139, 308–315. [Google Scholar] [CrossRef]
- Wright, P.; Jackson, N. Safety of engineered nanomaterials and occupational health and safety issues for commercial scale production. In Handbook of Clinical Nanomedicine: Law, Business, Regulation, Safety, and Risk; Bawa, R., Audette, G., Reese, B., Eds.; Pan Stanford Publishing: Singapore, 2016; pp. 569–619. [Google Scholar]
- Reshma, V.G.; Mohanan, P.V. Cellular interactions of zinc oxide nanoparticles with human embryonic kidney (HEK 293) cells. Colloids Surf. B 2017, 157, 182–190. [Google Scholar]
- Feltis, B.N.; OKeefe, S.J.; Harford, A.J.; Piva, T.J.; Turney, T.W.; Wright, P.F.A. Independent cytotoxic and inflammatory responses to zinc oxide nanoparticles in human monocytes and macrophages. Nanotoxicology 2012, 6, 757–765. [Google Scholar] [CrossRef]
- Alaraby, M.; Annangi, B.; Hernandez, A.; Creus, A.; Marcos, R. A comprehensive study of the harmful effects of ZnO nanoparticles using Drosophila melanogaster as an in vivo model. J. Hazard. Mater. 2015, 296, 166–174. [Google Scholar] [CrossRef]
- Wright, P.F.A. Realistic Exposure Study Assists Risk Assessments of ZnO Nanoparticle Sunscreens and Allays Safety Concerns. J. Investig. Dermatol. 2019, 139, 277–278. [Google Scholar] [CrossRef] [PubMed]
- Oprea, O.; Andronescu, E.; Vasile, B.S.; Voicu, G.; Covaliu, C. Synthesis and Characterization of Zno Nanopowder by Non-Basic Route. Dig. J. Nanomater. Biostruct. 2011, 6, 1393–1401. [Google Scholar]
- Anuar, M.F.; Fen, Y.W.; Zaid, M.H.M.; Omar, N.A.S.; Khaidir, R.E.M. Sintering Temperature Effect on Structural and Optical Properties of Heat Treated Coconut Husk Ash Derived SiO2 Mixed with ZnO Nanoparticles. Materials 2020, 13, 2555. [Google Scholar] [CrossRef] [PubMed]
- Beitollahi, H.; Tajik, S.; Nejad, F.G.; Safaei, M. Recent advances in ZnO nanostructure-based electrochemical sensors and biosensors. J. Mater. Chem. B 2020, 8, 5826–5844. [Google Scholar] [CrossRef]
- Amakali, T.; Daniel, L.S.; Uahengo, V.; Dzade, N.Y.; de Leeuw, N.H. Structural and Optical Properties of ZnO Thin Films Prepared by Molecular Precursor and Sol-Gel Methods. Crystals 2020, 10, 132. [Google Scholar] [CrossRef]
- Abderrahmane, B.; Djamila, A.; Chaabia, N.; Fodil, R. Improvement of ZnO nanorods photoelectrochemical, optical, structural and morphological characterizations by cerium ions doping. J. Alloys Compd. 2020, 829, 154498. [Google Scholar] [CrossRef]
- Vasile, B.S.; Vasile, O.R.; Ghitulica, D.C.; Ilie, F.C.; Nicoara, I.F.; Trusca, R.; Oprea, O.C.; Surdu, V.A.; Neacsu, I.A. Eu3+-doped ZnO nanostructures: Advanced characterizations, photoluminescence and cytotoxic effect. Rom. J. Morphol. Embryol. 2017, 58, 941–952. [Google Scholar]
- Khranovskyy, V.; Lazorenko, V.; Lashkarev, G.; Yakimova, R. Luminescence anisotropy of ZnO microrods. J. Lumin. 2012, 132, 2643–2647. [Google Scholar] [CrossRef]
- Galdamez-Martinez, A.; Santana, G.; Guell, F.; Martinez-Alanis, P.R.; Dutt, A. Photoluminescence of ZnO Nanowires: A Review. Nanomaterials 2020, 10, 857. [Google Scholar] [CrossRef]
- Munoz-Aguirre, N.; Martinez-Perez, L.; Munoz-Aguirre, S.; Flores-Herrera, L.A.; Hernandez, E.V.; Zelaya-Angel, O. Luminescent Properties of (004) Highly Oriented Cubic Zinc Blende ZnO Thin Films. Materials 2019, 12, 3314. [Google Scholar] [CrossRef]
- Zhang, M.; Averseng, F.; Krafft, J.M.; Borghetti, P.; Costentin, G.; Stankic, S. Controlled Formation of Native Defects in Ultrapure ZnO for the Assignment of Green Emissions to Oxygen Vacancies. J. Phys. Chem. C 2020, 124, 12696–12704. [Google Scholar] [CrossRef]
- Janotti, A.; Van de Walle, C.G. Native point defects in ZnO. Phys. Rev. B 2007, 76, 165202. [Google Scholar] [CrossRef]
- Oprea, O.; Vasile, O.R.; Voicu, G.; Andronescu, E. The Influence of the Thermal Treatment on Luminescence Properties of Zno. Dig. J. Nanomater. Biostruct. 2013, 8, 747–756. [Google Scholar]
- Vaja, F.; Comanescu, C.; Oprea, O.; Ficai, D.; Guran, C. Effects of ZnO Nanoparticles on the Wet Scrub Resistance and Photocatalytic Properties of Acrylic Coatings. Revista De Chimie 2012, 63, 722–726. [Google Scholar]
- Oprea, O.; Vasile, O.R.; Voicu, G.; Craciun, L.; Andronescu, E. Photoluminescence, Magnetic Properties and Photocatalytic Activity of Gd3+ Doped Zno Nanoparticles. Dig. J. Nanomater. Biostruct. 2012, 7, 1757–1766. [Google Scholar]
- Voicu, G.; Oprea, O.; Vasile, B.S.; Andronescu, E. Photoluminescence and Photocatalytic Activity of Mn-Doped Zno Nanoparticles. Dig. J. Nanomater. Biostruct. 2013, 8, 667–675. [Google Scholar]
- Nada, A.A.; Tantawy, H.R.; Elsayed, M.A.; Bechelany, M.; Elmowafy, M.E. Elaboration of nano titania-magnetic reduced graphene oxide for degradation of tartrazine dye in aqueous solution. Solid State Sci. 2018, 78, 116–125. [Google Scholar] [CrossRef]
- Nada, A.A.; El Rouby, W.M.A.; Bekheet, M.F.; Antuch, M.; Weber, M.; Miele, P.; Viter, R.; Roualdes, S.; Millet, P.; Bechelany, M. Highly textured boron/nitrogen co-doped TiO2 with honeycomb structure showing enhanced visible-light photoelectrocatalytic activity. Appl. Surf. Sci. 2020, 505, 144419. [Google Scholar] [CrossRef]
- Blazeka, D.; Car, J.; Klobucar, N.; Jurov, A.; Zavasnik, J.; Jagodar, A.; Kovacevic, E.; Krstulovic, N. Photodegradation of Methylene Blue and Rhodamine B Using Laser-Synthesized ZnO Nanoparticles. Materials 2020, 13, 4357. [Google Scholar] [CrossRef]
- Iqbal, A.; Ibrahim, N.H.; Rahman, N.R.A.; Saharudin, K.A.; Adam, F.; Sreekantan, S.; Yusop, R.M.; Jaafar, N.F.; Wilson, L.D. ZnO Surface Doping to Enhance the Photocatalytic Activity of Lithium Titanate/TiO2 for Methylene Blue Photodegradation under Visible Light Irradiation. Surfaces 2020, 3, 301–318. [Google Scholar] [CrossRef]
- Vinayagam, R.; Selvaraj, R.; Arivalagan, P.; Varadavenkatesan, T. Synthesis, characterization and photocatalytic dye degradation capability of Calliandra haematocephala-mediated zinc oxide nanoflowers. J. Photochem. Photobiol. B Biol. 2020, 203, 111760. [Google Scholar] [CrossRef] [PubMed]
- Yu, Y.; Yao, B.H.; He, Y.Q.; Cao, B.Y.; Ma, W.; Chang, L.L. Oxygen defect-rich In-doped ZnO nanostructure for enhanced visible light photocatalytic activity. Mater. Chem. Phys. 2020, 244, 122672. [Google Scholar] [CrossRef]
- Zgura, I.; Preda, N.; Enculescu, M.; Diamandescu, L.; Negrila, C.; Bacalum, M.; Ungureanu, C.; Barbinta-Patrascu, M.E. Cytotoxicity, Antioxidant, Antibacterial, and Photocatalytic Activities of ZnO-CdS Powders. Materials 2020, 13, 182. [Google Scholar] [CrossRef] [PubMed]
- Viswanathan, K.; Kim, I.; Kasi, G.; Sadeghi, K.; Thanakkasaranee, S.; Seo, J. Facile approach to enhance the antibacterial activity of ZnO nanoparticles. Adv. Appl. Ceram. 2020, 119, 414–422. [Google Scholar] [CrossRef]
- Ibrahim, N.A.; Nada, A.A.; Hassabo, A.G.; Eid, B.M.; El-Deen, A.M.; Abou-Zeid, N.Y. Effect of different capping agents on physicochemical and antimicrobial properties of ZnO nanoparticles. Chem. Pap. 2017, 71, 1365–1375. [Google Scholar] [CrossRef]
- Zhao, Y.J.; Zhang, C.X.; Folly, Y.M.E.; Chang, J.H.; Wang, Y.; Zhou, L.; Zhang, H.P.; Liu, Y. Morphological and Transcriptomic Analysis of the Inhibitory Effects of Lactobacillus plantarum on Aspergillus flavus Growth and Aflatoxin Production. Toxins 2019, 11, 636. [Google Scholar] [CrossRef]
- Jeong, M.J.; Kang, K.Y.; Bacher, M.; Kim, H.J.; Jo, B.M.; Potthast, A. Deterioration of ancient cellulose paper, Hanji: Evaluation of paper permanence. Cellulose 2014, 21, 4621–4632. [Google Scholar] [CrossRef]
- Kubovsky, I.; Kacikova, D.; Kacik, F. Structural Changes of Oak Wood Main Components Caused by Thermal Modification. Polymers 2020, 12, 485. [Google Scholar] [CrossRef]
- Lemnaru, G.M.; Trusca, R.D.; Ilie, C.I.; Tiplea, R.E.; Ficai, D.; Oprea, O.; Stoica-Guzun, A.; Ficai, A.; Ditu, L.M. Antibacterial Activity of Bacterial Cellulose Loaded with Bacitracin and Amoxicillin: In Vitro Studies. Molecules 2020, 25, 4069. [Google Scholar] [CrossRef]
- Motelica, L.; Craciun, L.; Ardelean, I.; Ioana, M.V. Non-destructive Analyses of 16th Century Documents. Revista De Chimie 2019, 70, 2798–2802. [Google Scholar] [CrossRef]
- Oyewo, O.A.; Adeniyi, A.; Sithole, B.B.; Onyango, M.S. Sawdust-Based Cellulose Nanocrystals Incorporated with ZnO Nanoparticles as Efficient Adsorption Media in the Removal of Methylene Blue Dye. ACS Omega 2020, 5, 18798–18807. [Google Scholar] [CrossRef] [PubMed]
- Zhang, X.L.; Ren, S.X.; He, X.F.; Dong, L.L.; Bai, W.; Lei, T.Z.; Chen, H. Preparation and Characterization of Cellulose Nanofiber/Zinc Oxide Composite Films. J. Biobased Mater. Bioenergy 2020, 14, 203–208. [Google Scholar] [CrossRef]
- Cole, C.G.B.; Roberts, J.J. The fluorescence of gelatin and its implications. Imaging Sci. J. 1997, 45, 145–149. [Google Scholar] [CrossRef]
- Cai, B.; Rao, L.; Ji, X.H.; Bu, L.L.; He, Z.B.; Wan, D.; Yang, Y.; Liu, W.; Guo, S.S.; Zhao, X.Z. Autofluorescent gelatin nanoparticles as imaging probes to monitor matrix metalloproteinase metabolism of cancer cells. J. Biomed. Mater. Res. A 2016, 104, 2854–2860. [Google Scholar] [CrossRef]
- Malinowska, K.H.; Rind, T.; Verdorfer, T.; Gaub, H.E.; Nash, M.A. Quantifying Synergy, Thermostability, and Targeting of Cellulolytic Enzymes and Cellulosomes with Polymerization-Based Amplification. Anal. Chem. 2015, 87, 7133–7140. [Google Scholar] [CrossRef]
- Yuan, W.Z.; Zhang, Y.M. Nonconventional Macromolecular Luminogens with Aggregation-Induced Emission Characteristics. J. Polym. Sci. A Polym. Chem. 2017, 55, 560–574. [Google Scholar] [CrossRef]
- Teixeira, F.J.; Castro, A.A.N.; Sant’Ana, A.C. Investigating the origin of the raw material of rag paper by Raman spectroscopy. Vib. Spectrosc. 2018, 98, 119–122. [Google Scholar] [CrossRef]
- Agarwal, U.P. Analysis of Cellulose and Lignocellulose Materials by Raman Spectroscopy: A Review of the Current Status. Molecules 2019, 24, 1659. [Google Scholar] [CrossRef]
- Castellan, A.; Ruggiero, R.; Frollini, E.; Ramos, L.A.; Chirat, C. Studies on fluorescence of cellulosics. Holzforschung 2007, 61, 504–508. [Google Scholar] [CrossRef]
- Fu, F.Y.; Li, L.Y.; Liu, L.J.; Cai, J.; Zhang, Y.P.; Zhou, J.P.; Zhang, L.N. Construction of Cellulose Based ZnO Nanocomposite Films with Antibacterial Properties through One-Step Coagulation. ACS Appl. Mater. Interfaces 2015, 7, 2597–2606. [Google Scholar] [CrossRef]
- Awan, F.; Islam, M.S.; Ma, Y.Y.; Yang, C.; Shi, Z.Q.; Berry, R.M.; Tam, K.C. Cellulose Nanocrystal-ZnO Nanohybrids for Controlling Photocatalytic Activity and UV Protection in Cosmetic Formulation. ACS Omega 2018, 3, 12403–12411. [Google Scholar] [CrossRef] [PubMed]
- Egbuta, M.A.; Mwanza, M.; Babalola, O.O. Health Risks Associated with Exposure to Filamentous Fungi. Int. J. Environ. Res. Public Health 2017, 14, 719. [Google Scholar] [CrossRef] [PubMed]
- El-Feky, O.M.; Hassan, E.A.; Fadel, S.M.; Hassan, M.L. Use of ZnO nanoparticles for protecting oil paintings on paper support against dirt, fungal attack, and UV aging. J. Cult. Herit. 2014, 15, 165–172. [Google Scholar] [CrossRef]
- Chen, J.B.; Ma, Y.Y.; Lin, H.P.; Zheng, Q.Z.; Zhang, X.X.; Yang, W.B.; Li, R. Fabrication of Hydrophobic ZnO/PMHS Coatings on Bamboo Surfaces: The Synergistic Effect of ZnO and PMHS on Anti-Mildew Properties. Coatings 2019, 9, 15. [Google Scholar] [CrossRef]
- Luo, Z.W.; Zhu, M.; Guo, M.L.; Lian, Z.Y.; Tong, W.; Wang, J.R.; Zhang, B.H.; Wei, W.J. Ultrasonic-Assisted Dispersion of ZnO Nanoparticles and Its Inhibition Activity to Trichoderma viride. J. Nanosci. Nanotechnol. 2018, 18, 2352–2360. [Google Scholar] [CrossRef]
- Wang, J.; Li, J.P.; Zhuang, X.W.; Pan, X.; Yu, H.X.; Sun, F.L.; Song, J.G.; Jin, C.D.; Jiang, Y.T. Improved mould resistance and antibacterial activity of bamboo coated with ZnO/graphene. R. Soc. Open Sci. 2018, 5, 180173. [Google Scholar] [CrossRef]
- Ren, D.J.; Li, J.P.; Bao, Y.J.; Wu, Z.X.; He, S.; Wang, A.K.; Guo, F.; Chen, Y.H. Low-temperature synthesis of flower-like ZnO microstructures supported on TiO2 thin films as efficient antifungal coatings for bamboo protection under dark conditions. Colloids Surf. A Physicochem. Eng. Asp. 2018, 555, 381–388. [Google Scholar] [CrossRef]

Publisher’s Note: MDPI stays neutral with regard to jurisdictional claims in published maps and institutional affiliations. |
© 2020 by the authors. Licensee MDPI, Basel, Switzerland. This article is an open access article distributed under the terms and conditions of the Creative Commons Attribution (CC BY) license (http://creativecommons.org/licenses/by/4.0/).
Share and Cite
Motelica, L.; Popescu, A.; Răzvan, A.-G.; Oprea, O.; Truşcă, R.-D.; Vasile, B.-S.; Dumitru, F.; Holban, A.-M. Facile Use of ZnO Nanopowders to Protect Old Manual Paper Documents. Materials 2020, 13, 5452. https://doi.org/10.3390/ma13235452
Motelica L, Popescu A, Răzvan A-G, Oprea O, Truşcă R-D, Vasile B-S, Dumitru F, Holban A-M. Facile Use of ZnO Nanopowders to Protect Old Manual Paper Documents. Materials. 2020; 13(23):5452. https://doi.org/10.3390/ma13235452
Chicago/Turabian StyleMotelica, Ludmila, Aurelian Popescu, Anca-Gabriela Răzvan, Ovidiu Oprea, Roxana-Doina Truşcă, Bogdan-Stefan Vasile, Florina Dumitru, and Alina-Maria Holban. 2020. "Facile Use of ZnO Nanopowders to Protect Old Manual Paper Documents" Materials 13, no. 23: 5452. https://doi.org/10.3390/ma13235452
APA StyleMotelica, L., Popescu, A., Răzvan, A.-G., Oprea, O., Truşcă, R.-D., Vasile, B.-S., Dumitru, F., & Holban, A.-M. (2020). Facile Use of ZnO Nanopowders to Protect Old Manual Paper Documents. Materials, 13(23), 5452. https://doi.org/10.3390/ma13235452

